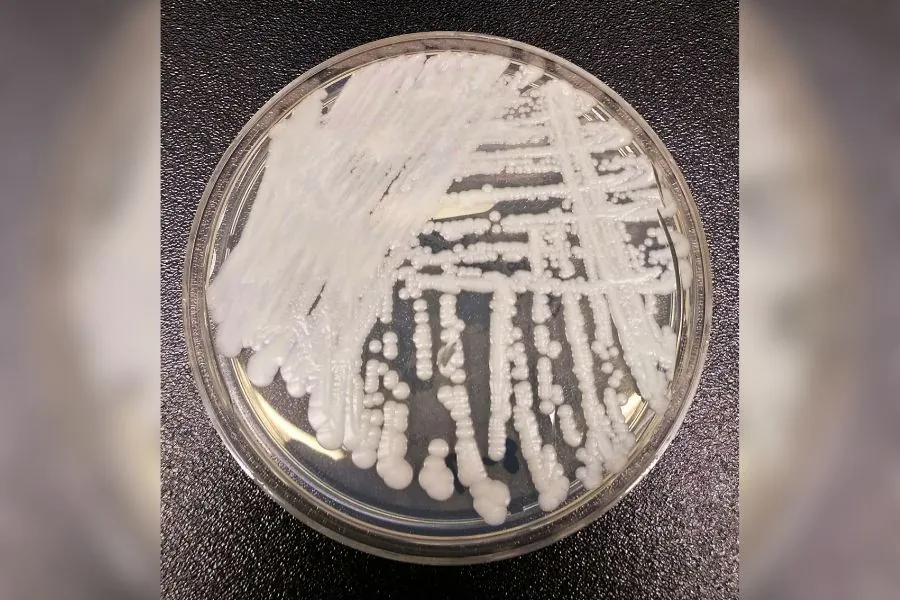

Mandato tampão: Fátima pode desistir de pré-candidatura se não tiver maioria na Assembleia

A possibilidade de renúncia da governadora Fátima Bezerra (PT) para disputar uma vaga no Senado em 2026 passou a ser tratada com cautela nos bastidores da política potiguar. Segundo apuração dos jornalistas Saulo Espinelly e Anna Karinna Castro, comentada no programa 12 em Ponto, da 98 FM Natal, cresce a avaliação de que Fátima só deixaria o cargo caso tivesse segurança sobre quem assumiria o governo em um eventual mandato tampão.
De acordo com Saulo Espinelly, interlocutores próximos à governadora apontam que a decisão de renunciar está diretamente condicionada ao controle do processo sucessório na Assembleia Legislativa do Rio Grande do Norte (ALRN). “Conversei com quatro pessoas, dois petistas históricos e dois que circulam na governadoria, e todos foram unânimes: se a governadora não tiver certeza de que conseguirá fazer o ‘tampão’, não acreditam que ela renuncie”, afirmou o comentarista.
A apuração também indica que o impasse gerou repercussão em Brasília. Segundo Espinelly, a ministra das Relações Institucionais, Gleisi Hoffmann, teria feito contatos com lideranças do MDB para tratar do posicionamento do partido. “Gleisi ligou para Baleia Rossi e conversou com ministros do MDB, como Jader Barbalho e Renan Filho, questionando a postura de Walter Alves e se a executiva nacional não iria se posicionar”, relatou.
Ainda conforme as informações, o caso teria sido encaminhado ao Tribunal Regional Eleitoral (TRE) e ao Tribunal Superior Eleitoral (TSE) para formalizar a ida do vice-governador Walter Alves (MDB). Para Espinelly, a movimentação foi uma sinalização política. “Foi uma resposta para mostrar que o MDB apoia o governo federal e o presidente Lula, mas que, nas decisões internas do partido, o PT não interfere”, disse.
Já a jornalista Anna Karinna Castro destacou que o presidente da Assembleia Legislativa, Ezequiel Ferreira, também aparece como peça central nesse cenário. Segundo ela, Ezequiel teria interesse em conduzir o processo, mas não em assumir o governo. “Ele vai conduzir esse processo, mas deixou claro que não assumiria nem provisoriamente”, afirmou.
A comentarista acrescentou ainda que fontes indicam uma aproximação de Ezequiel com grupos de oposição ao governo estadual. “Há relatos de que ele estaria trabalhando para montar a nominata proporcional do Republicanos”, disse.
Para Anna Karinna, esse movimento sinaliza um distanciamento do projeto político da governadora. “Se a oposição já conta com pelo menos 11 votos e o presidente da Assembleia se aproxima desse grupo, a governadora passa a ter muita dificuldade para renunciar e emplacar um nome alinhado ao seu campo político”, avaliou.
Diante desse cenário, cresce nos bastidores a hipótese de que Fátima Bezerra opte por permanecer no cargo até o fim do mandato, abrindo mão, ao menos por ora, da pré-candidatura ao Senado, caso não haja garantia de maioria na Assembleia para assegurar um governo tampão favorável ao seu grupo político.
[VÍDEO] Parte da bancada federal do RN decide corte de R$ 27 milhões em emendas sem consultar todos os parlamentares
Uma decisão tomada por parte da bancada federal do Rio Grande do Norte resultou no corte de R$ 27,9 milhões em emendas parlamentares sem o conhecimento ou participação de todos os parlamentares. Compartilhei essa informação durante o programa 12 em Ponto, da 98 FM Natal.
Segundo o apurado, o Governo Federal comunicou oficialmente todas as bancadas estaduais sobre o contingenciamento e estabeleceu dois critérios possíveis para a distribuição do corte: proporcional entre todos os membros ou direcionado, desde que houvesse quórum qualificado, com maioria dos deputados e dois terços dos senadores.
No caso do RN, a opção adotada teria sido a distribuição direcionada, definida por meio de planilha, mas sem consulta a parte dos parlamentares. Os parlamentares que não foram avisados sobre a decisão do corte de emendas são os senadores Rogério Marinho e Styvenson Valentim, além dos deputados federais Carla Dickson, General Girão e Sargento Gonçalves. Nenhum deles foi consultado ou assinou o documento que definiu a distribuição direcionada do contingenciamento, tomando conhecimento da medida apenas após o envio do documento ao Ministério do Planejamento.
O corte atingiu de forma mais intensa a capital potiguar. Natal perdeu cerca de R$ 9,6 milhões em recursos destinados à saúde, provenientes de emendas já empenhadas. A condução do processo, sem debate interno e sem distribuição linear, gerou impacto direto em áreas consideradas prioritárias e levanta questionamentos sobre a atuação da coordenação da bancada.
Confira, no início do post, o recorte do programa onde trago a informação.
Styvenson ataca bancada do RN e chama corte de emenda para Natal de “coisa de gente bandida e safada”

O senador Styvenson Valentim (PSDB) voltou a endurecer o discurso contra a bancada federal do Rio Grande do Norte após o cancelamento de uma emenda parlamentar de R$ 12,6 milhões destinada à Prefeitura do Natal. Em vídeo divulgado nas redes sociais nesta segunda-feira (26), o parlamentar classificou a decisão como “picuinha política”, “inveja” e “tratamento de gente bandida e safada na política”.
Segundo Styvenson, o corte foi decidido internamente pela bancada potiguar sem a sua participação e sem transparência. O senador afirmou que a medida atingiu diretamente recursos indicados por seu mandato e sugeriu que o bloqueio teve motivação política. “Cortaram R$ 12 milhões da Prefeitura do Natal. Deve ser problema político, retaliação, mesquinharia, picuinha política”, declarou.
Na semana passada, Styvenson já havia acionado o ministro Flávio Dino, do Supremo Tribunal Federal (STF), para questionar a forma como a decisão foi tomada. Ele argumenta que, diante do contingenciamento promovido pelo Governo Federal em novembro de 2025, defendia um corte linear entre todos os parlamentares. No entanto, segundo o senador, a maioria da bancada optou por concentrar o enxugamento em emendas de sua autoria.
O contingenciamento total imposto às emendas da bancada do RN foi de R$ 27,9 milhões. Para atender à determinação, a emenda de R$ 12,6 milhões destinada à Prefeitura do Natal foi cancelada, restando apenas R$ 3,3 milhões disponíveis.
Styvenson rebateu críticas de que estaria reagindo por interesse pessoal e afirmou que o impacto do corte atinge toda a população. “Perde tu, deputado federal, R$ 9 milhões. Perde tu, senador, R$ 9 milhões. Se tivesse dado um corte na tua emenda, tu estaria calado?”, questionou. Segundo ele, os recursos seriam utilizados em serviços de saúde localizados em Natal, mas que atendem pacientes de todo o estado.
“Por que não cortou de todo mundo e cortou só de Styvenson? É inveja? Está sentindo o quê? Aperreio, porque não fez no mandato todinho, no histórico político todinho, não fez nada comparado com o que a gente fez até aqui”, disse.
Ao explicar o acionamento do STF, o senador citou a ADPF 854 e afirmou ter comunicado ao ministro Flávio Dino a ausência de procedimentos formais na decisão. “Eu mandei sim para o STF. Apenas informei ao ministro a falta de transparência da bancada federal, que fez esse corte sem a concordância de dois senadores, eu e Rogério Marinho (PL)”, declarou. Segundo Styvenson, havia uma proposta de corte linear sugerida pela Comissão Mista de Orçamento, que não teria sido seguida.
O parlamentar também criticou o impacto do bloqueio sobre municípios que dependem das emendas. “Foi para prejudicar você, cidadão. Vai afetar muitos outros municípios que dependem de recursos do meu mandato”, afirmou, pedindo que apoiadores compartilhassem o vídeo.
Questionamentos formais
No documento enviado ao STF, Styvenson questiona a forma como a bancada potiguar definiu a distribuição dos cortes e afirma que não participou das deliberações. Segundo ele, a decisão não observou critérios legais de colegialidade, transparência e rastreabilidade.
De acordo com o senador, o contingenciamento foi encaminhado à Secretaria de Relações Institucionais (SRI) do Governo Federal por meio de uma “mera planilha”, sem reunião formal, sem ata, sem quórum qualificado e sem registro nominal de votos.
O parlamentar sustenta que o Congresso exige que decisões sobre emendas sejam tomadas em reuniões oficiais, com aprovação qualificada e publicação das atas, identificando os responsáveis pelas deliberações. No ofício, Styvenson aponta que a condução do processo teria atendido aos interesses de um grupo específico da bancada potiguar, formado pelos deputados Robinson Faria (PP), Benes Leocádio (União Brasil), Natália Bonavides (PT), Fernando Mineiro (PT) e João Maia (PP), além da senadora Zenaide Maia (PSD).
A reportagem procurou o coordenador da bancada federal do RN, deputado Robinson Faria, e aguarda posicionamento.
As informações são do Agora RN
Interdição na Avenida das Fronteiras altera rotas de ônibus temporariamente

A Avenida das Fronteiras, localizada na Zona Norte de Natal, foi interditada nesta segunda-feira (26) para a realização de obras de saneamento conduzidas pela Companhia de Águas e Esgotos do Rio Grande do Norte (Caern).
O trecho fechado abrange a área entre as ruas Irmã Vitória e Henrique Dias. Segundo a Secretaria de Mobilidade Urbana (STTU), a interdição deve se manter até 15 de fevereiro.
De acordo com a Caern, a ação é necessária para a interligação do sistema de esgotamento sanitário da Zona Norte. Ao todo, serão implantados 250 metros de tubulação na região, sendo 70 metros na Avenida das Fronteiras, beneficiando os bairros e conjuntos: Nossa Senhora da Apresentação, Panatis I, II e III, Vale Dourado e Vila Paraíso.
As obras incluem a instalação de tubulação de 400 mm de diâmetro a cerca de 4 metros de profundidade, o que torna indispensável a interrupção total do tráfego e a implantação de desvios viários.
Alterações no transporte público
Com a interdição, algumas linhas de ônibus urbano terão itinerários temporários, conforme divulgado pela STTU:
Linhas N-05 e N-72
- Sentido Ribeira/Mirassol (desvio): Avenida Belarmino Tomaz Landim → Rua Ponte Nova → Rua Henrique Dias → Rua Vivaldo Cavalcanti → itinerário normal.
- Sentido Vale Dourado: sem alterações.
Linha S-50
- Sentido Santa Catarina (desvio): Avenida das Fronteiras → Rua Antônio Viana → Avenida Santarém → Rua Ponte Nova → Rua Santa Luzia → Rua Presidente Médici → itinerário normal.
- Sentido Serrambi: sem alterações.
A STTU reforça que as mudanças são temporárias e visam garantir a segurança viária durante a execução das obras. Agentes de mobilidade estarão presentes para orientar motoristas e usuários do transporte público durante o período de interdição.
Fonte: 98 FM
Valdemar Costa Neto aponta aliados centrais de Flávio Bolsonaro e deixa Rogério Marinho fora da lista

O presidente nacional do PL, Valdemar Costa Neto, afirmou neste domingo (25) que o deputado federal Nikolas Ferreira (PL-MG) será um dos principais nomes da campanha do senador Flávio Bolsonaro à Presidência da República. A declaração foi feita em entrevista à coluna da jornalista Milena Teixeira, no portal Metrópoles.
De acordo com Costa Neto, além de Nikolas Ferreira, o governador de São Paulo, Tarcísio de Freitas (Republicanos), e a ex-primeira-dama Michelle Bolsonaro também devem exercer papéis estratégicos na campanha presidencial. O dirigente classificou o trio como peças-chave para a disputa eleitoral prevista para outubro.
Na fala do presidente do PL, chamou atenção a ausência do nome do senador Rogério Marinho. O parlamentar potiguar chegou a deixar a disputa pelo Governo do Rio Grande do Norte para assumir a coordenação da campanha presidencial de Flávio Bolsonaro, mas não foi citado por Valdemar Costa Neto entre os principais articuladores do projeto eleitoral.
A declaração gerou repercussão nos bastidores políticos, especialmente no Rio Grande do Norte, onde Rogério Marinho é uma das principais lideranças do campo bolsonarista. Até o momento, nem o senador nem a direção estadual do PL se manifestaram sobre a fala do presidente nacional do partido.
Flávio Bolsonaro, filho do ex-presidente Jair Bolsonaro, é apontado por aliados como o nome do grupo para a corrida presidencial, enquanto o partido articula a estratégia e define os principais rostos da campanha.
Justiça condena Estado a pagar aluguéis e IPTU de imóvel usado pelo Itep na Ribeira
A 4ª Vara da Fazenda Pública de Natal julgou procedente uma ação de cobrança e condenou o Estado do Rio Grande do Norte a pagar aluguéis atrasados e o IPTU de um imóvel localizado na Avenida Duque de Caxias, no bairro da Ribeira, utilizado para abrigar setores do Instituto Técnico-Científico de Perícia (Itep).
De acordo com a decisão, o Estado deverá quitar os aluguéis referentes aos meses de agosto, setembro e outubro de 2025, além do IPTU do exercício de 2025. O imóvel é utilizado para o funcionamento de unidades administrativas e operacionais do Itep e possui contrato de locação firmado inicialmente em 2013, com prorrogações ao longo dos anos.
Na ação, o proprietário do imóvel alegou atrasos no pagamento dos aluguéis e o acúmulo de débitos de IPTU e taxas municipais. Conforme apontado no processo, uma consulta ao site da Secretaria Municipal de Tributação indicava a existência de débitos de IPTU e taxa de lixo referentes aos anos de 2016, 2017, 2019, 2020, 2021, 2022, 2023 e 2024, que somavam R$ 148.797,22.
Durante a análise do caso, o magistrado destacou que as dívidas inicialmente discutidas no processo, incluindo aluguéis de 2023 e de janeiro de 2024, além dos IPTUs de exercícios anteriores, foram quitadas pelo Estado ao longo da tramitação da ação. Documentos anexados aos autos comprovaram o pagamento de mais de R$ 110 mil em tributos atrasados.
Segundo a sentença, permaneceram pendentes apenas os aluguéis dos meses de agosto, setembro e outubro de 2025 e o IPTU do mesmo ano. Como o contrato estava em vigor nesse período e o imóvel continuou sendo utilizado para a prestação de serviços públicos, o juiz reconheceu a obrigação do Estado de arcar com os valores restantes.
A decisão determinou que os aluguéis sejam calculados com base no valor mensal previsto no 10º Termo Aditivo do contrato, no montante de R$ 10.288,72, com atualização pela Taxa Selic. Também foi autorizada a dedução de eventuais valores pagos administrativamente. Além disso, o Estado foi condenado ao pagamento de honorários advocatícios fixados em 10% sobre o valor da condenação.
Fonte: 98 FM Natal
Sesap confirma caso de super fungo Candida auris em paciente internado em hospital de Natal
A Secretaria de Estado da Saúde Pública (Sesap) confirmou a identificação do fungo Candida auris em um paciente internado no Hospital Central Coronel Pedro Germano (Hospital da PM). A confirmação ocorreu após a realização de dois exames no Laboratório Central do Estado.
De acordo com a Sesap, o paciente é um homem que permanece em isolamento hospitalar e está sendo tratado por outra enfermidade. As equipes da unidade de saúde adotaram protocolos para evitar a contaminação de outros pacientes e dos profissionais que atuam no hospital.
As equipes de vigilância em saúde do Estado também realizam o monitoramento e o rastreio do caso. Segundo a pasta, a contaminação pelo fungo ocorre apenas por contato direto e não apresenta alto nível de transmissibilidade.
Com Cidade do Forró destaque nacional, Derradeiro de Maio abre vendas para 4ª edição

A Cidade do Forró, que fica na Fazenda Tome Xote, em Olho d’Água do Borges, vem ganhando relevância no Brasil e neste fim de semana vai ser destaque nacional mais uma vez neste fim de semana. Pelo quarto ano seguido, o local sedia o Derradeiro de Maio, evento que abre o São João no Nordeste.
E este ano, o projeto idealizado pelo cantor e compositor Dorgival Dantas acontece em dois dias (15 e 16 de maio) com a venda de ingressos iniciada na quinta-feira (22), no site Evenyx.
A Cidade do Forró foi criada para valorizar a cultura nordestina e o forró com o projeto Derradeiro de Maio fortalecendo isso trazendo uma programação formada por grandes artistas e a abertura da época mais aguardada pelo nordestino.
No site Evenyx é possível ver as áreas da festa e os ingressos à venda. Mais informações no perfil oficial @fazendatomexote no Instagram.
MDB nacional prorroga mandato do diretório estadual no RN até 2027

A direção nacional do Movimento Democrático Brasileiro (MDB) decidiu prorrogar o mandato do Diretório Estadual do partido no Rio Grande do Norte até o dia 15 de março de 2027. A decisão foi assinada pelo presidente nacional da legenda, deputado federal Baleia Rossi, e já foi comunicada à Justiça Eleitoral e ao Tribunal Regional Eleitoral do RN (TRE-RN).
De acordo com o documento, a prorrogação atende a um pedido formal do próprio diretório potiguar e tem como objetivo assegurar a continuidade da representação partidária no estado, levando em consideração os interesses das lideranças locais. O mandato anterior da direção estadual venceria em 30 de outubro de 2025, mas foi estendido com base nas prerrogativas previstas no Estatuto do MDB.
Na decisão, Baleia Rossi ressalta que o tema se enquadra no âmbito das matérias internas do partido, amparadas pela autonomia partidária garantida pela Constituição Federal e pela legislação eleitoral. O texto também informa que a medida será submetida posteriormente ao referendo da Comissão Executiva Nacional do MDB.
Com a prorrogação, o vice-governador Walter Alves permanece na presidência do Diretório Estadual do MDB no Rio Grande do Norte. Conforme certidão emitida pela Justiça Eleitoral nesta sexta-feira (23), Walter Alves figura como membro titular do diretório estadual e delegado à convenção nacional do partido, com mandato válido entre 4 de novembro de 2023 e 15 de março de 2027.
A manutenção da atual direção ocorre em meio às articulações políticas relacionadas às eleições de 2026 no estado. A decisão da executiva nacional reforça a permanência de Walter Alves no comando formal da legenda durante o próximo ciclo eleitoral e sinaliza uma estratégia de estabilidade interna do MDB no Rio Grande do Norte.
Deputados Girão e Gonçalves participam de “Caminhada pela Liberdade” liderada por Nikolas Ferreira em apoio a Bolsonaro

Os deputados federais do Rio Grande do Norte General Girão (PL) e Sargento Gonçalves (PL) participam da chamada “Caminhada pela Liberdade”, mobilização liderada pelo deputado federal Nikolas Ferreira (PL-MG). O ato tem como principal bandeira a defesa da liberdade do ex-presidente Jair Bolsonaro.
A caminhada teve início na última segunda-feira (19), em Paracatu, município de Minas Gerais próximo à divisa com o estado de Goiás. O grupo percorre pouco mais de 200 quilômetros a pé, com previsão de chegada ao Distrito Federal no próximo domingo (25).
Ao longo do trajeto, a mobilização tem reunido parlamentares e apoiadores que defendem pautas relacionadas à liberdade, à justiça e ao apoio político ao ex-presidente. A iniciativa vem ganhando repercussão nas redes sociais, onde os participantes compartilham registros do percurso e mensagens de mobilização.
Em publicação nas redes, o deputado General Girão destacou o simbolismo do ato. “Lutar pelo nosso Brasil e defender a justiça e a liberdade não tem preço. Seguimos firmes no propósito e focados na missão”, escreveu.
A expectativa dos organizadores é que a chegada a Brasília concentre apoiadores e amplie a visibilidade do movimento, que ocorre em meio a debates políticos e judiciais envolvendo o ex-presidente Jair Bolsonaro.

Parabéns prefeito @paulinhofeire, pelo belíssimo carnaval 👏👏👏👏👏
Álvaro Dias será se Deus quiser o melhor para reconstruir o RN o mesmo que fez por Natal se Deus…
Que notícia maravilhosa 👏🏻👏🏻👏🏻